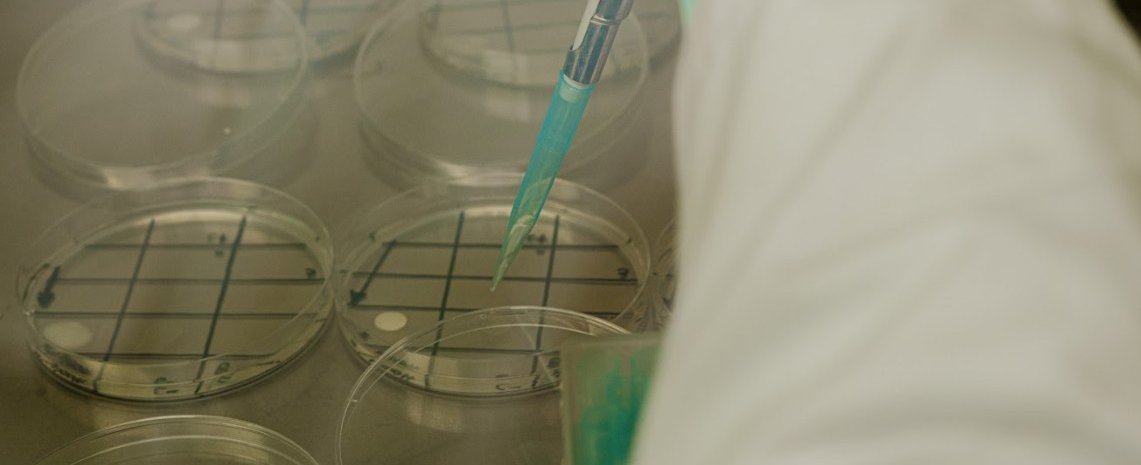

Nuestros análisis se realizan bajo metodologías estandarizadas y normas internacionales, asegurando resultados confiables y comparables.
Estos ensayos permiten validar la eficacia de formulaciones con propiedades antimicrobianas, verificar condiciones higiénicas en superficies, apoyar procesos de control de calidad y respaldar el desarrollo de productos innovadores para la industria de alimentos, envases, cosmética y aplicaciones industriales. Además, entregan información clave para comparar proveedores, optimizar procesos y garantizar el cumplimiento de requisitos técnicos y regulatorios.
Recuentos y Detección de Microorganismos en Superficies
Realizamos análisis microbiológicos destinados a cuantificar y detectar microorganismos indicadores y patógenos presentes en superficies asociadas a procesos productivos, materiales de envase, equipos y ambientes industriales. Estos ensayos permiten evaluar condiciones higiénicas, validar procesos de limpieza y desinfección, y garantizar el cumplimiento de estándares microbiológicos aplicables a la industria alimentaria y de envases. Nuestros métodos se basan en técnicas microbiológicas reconocidas, que permiten obtener resultados reproducibles y comparables. Esto es especialmente relevante para empresas que deben demostrar control sanitario, verificar materias primas o evaluar el desempeño higiénico de materiales utilizados en contacto con alimentos.
Ejemplos de análisis realizados:
Entre los microorganismos evaluados se incluyen aerobios mesófilos, mohos y levaduras, enterobacterias y patógenos como Staphylococcus aureus, Salmonella, Listeria monocytogenes o E. coli.
Ensayos de Capacidad Antimicrobiana
Contamos con ensayos específicos para evaluar la capacidad antimicrobiana de materiales, recubrimientos, soluciones tecnológicas y productos innovadores. Estos estudios permiten determinar si un material inhibe o reduce el crecimiento de microorganismos mediante contacto directo o bajo condiciones normalizadas. Utilizamos metodologías basadas en normas internacionales, como ASTM 2149, que garantizan confiabilidad en la medición del desempeño antimicrobiano. Los resultados obtenidos son útiles para la validación técnica de materiales funcionales, desarrollo de envases activos, optimización de formulaciones y generación de evidencia científica para proyectos de I+D.
Ejemplos de microorganismos evaluados:
Trabajamos con microorganismos indicadores y patógenos modelo, como Botrytis cinerea, E. coli, Staphylococcus aureus y Listeria innocua, Staphilococus aureus según norma ASTM 2149.